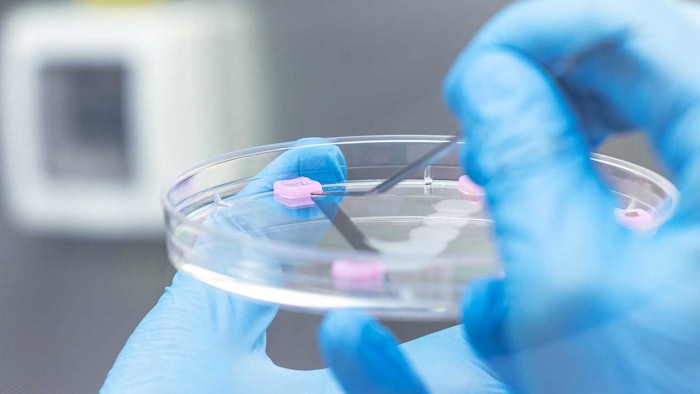

Gattefossé and CTIBiotech have developed Bioimpedance 3D Bioprinted skin chips to link cosmetics lab testing to humans. The models allow for the non-invasive measurement of sebum production and should improve the predictivity of in vitro tests of sebum-regulating ingredients, according to the companies.
Sebum is a complex lipids mixture secreted by sebocytes and deposited in stratum corneum for helping the skin barrier function. The disruption of sebum production leads to common skin diseases, including acne or atopic dermatitis, the companies report; it also contributes to the development of oily or dry skin and impacts both the appearance and beauty of skin.
Solutions to address these issues and develop more efficient cosmetics still require more predictive testing ranging from lab data to humans, the companies add. Furthermore, successful lab-to-donor data is reportedly not easy to obtain and often fails due to improper translational readouts. Gattefossé and CTIBiotech therefore worked together to develop a 3D bio-printed model integrating sebocytes for measuring non-invasive parameters in vitro on real humans while at the same time giving laboratory readouts.
Bioimpedance (also known as bioelectrical impedance analysis) has been widely used to monitor personal health and body composition, and to adjust diet and lifestyles accordingly. Using connected scales, Gattefossé and CTIBiotech leveraged bioimpedance to evaluate changes in the local environment of a 3D skin model integrating sebocytes.
As a result, the measurement of such a non-invasive electrical activity allowed the companies to follow, in real-time, sebum production, in addition to laboratory readouts dealing with cellular, matrix and tissue development.









